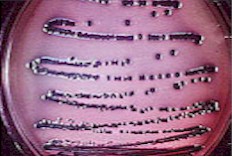
petri2.jpg (16053 bytes)

|
"How can a microorganism like
gonococci persist in a human population when it is continuously exposed to the immune
system, and thus should be killed?"
--N.
gonorrhea: a model for bacterial infection...--
Somehow this bacterium
must have learned to cope with our immune system since the bacteria is found in up to
1/250 of all individuals, depending on the geographical location!
 Gonorrhea
Course of Infection Gonorrhea
Course of Infection
|
- The bacteria first gain entry in to the
human urethra
- Then adheres to epithelial cells (cells on
the surface)
- Invade (enter them)
- Arrive at the basal membrane where they
cause an acute purulent infection that leads to..
- Secretion of pus in infected males and...
- Note, the symptoms of female gonorrhea are
more discrete, thus making the disease difficult to diagnose.
|

 What we
do in our defense... (Though, obviously not enough...) What we
do in our defense... (Though, obviously not enough...)
|
- Massive amounts of macrophages and
neutrophils (also know as bacteria eaters) kill the gonococcal bacteria
- We also raise antibodies to seek and aid in
the destruction of the bacteria
|
I promised you genetics
earlier, and I wasn't kidding!
|Home|Back|
|